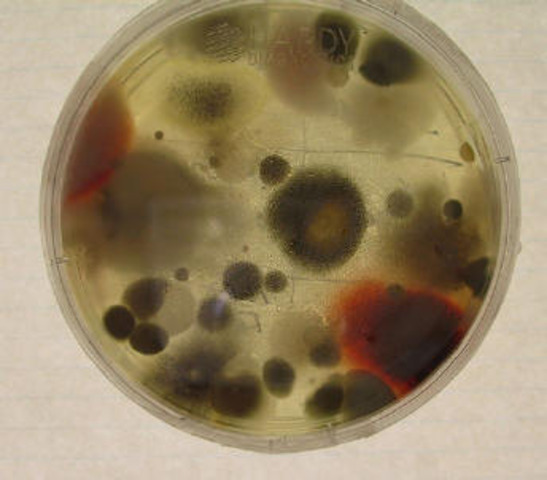
Mouldy Bacteria

-
-
In the 1920's Fleming was searching for an effective antiseptic. He discoverd lysozome in this time which is a enzyme that is found naturally in sweat and tears. He also found that the enzyme is unable to tackle the stogest infections.
-
After his discovery there was a lot of mayhem and this often meant that Fleming's lab was in a mess. This proved to be very fortunate in his path to discovering penicilin.
-
He used some petri dishes that he had found while cleaning up his lab that had bacteria growing inside. He took a look at one of the dishes and found that all round the mould the bacteria that he had been growing was dead.
-
Fleming wondered if the mould which was called Penicillium notatum had killed the bacteria. To try and prove this he set up a control experiment. He had 2 petri dishes, one that contained both the bacteria and mould and one that contained only bacteria. When he looked back at the dishes the bacteria with mould was dead but the other bacteria was still growing. This prved that he was rght.
-
Fleming then spent many year studying the mould and discovered that it was a non-toxic and it could be used successfully to control many different types of bacteria
-
Fleming never did have the resources to try and continue with his mould reaserch and when he died in 1955 he left behind the world as a man who had discovered one of the most important antibiotcs that we still use today.
Plan projects on a visual timeline
Map milestones, phases, deadlines, and key events in one place so the sequence is easier to see and share. Timetoast is a timeline maker for work, school, research, and stories.